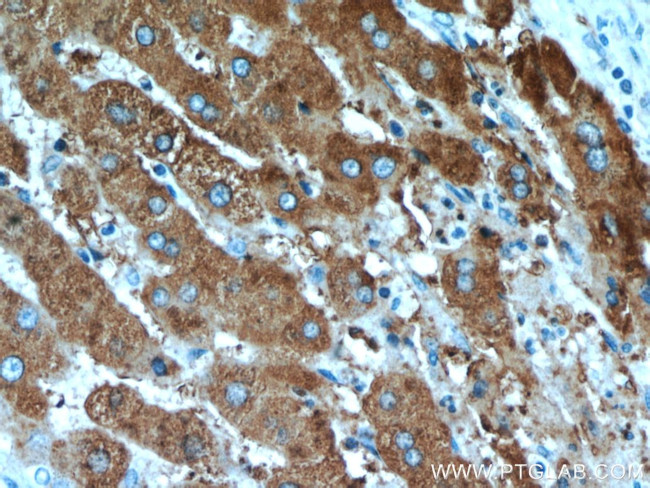
TRMT2B Antibody in Immunohistochemistry (Paraffin) (IHC (P))

Search
Proteintech
TRMT2B Polyclonal Antibody
{{$productOrderCtrl.translations['antibody.pdp.commerceCard.promotion.promotions']}}
{{$productOrderCtrl.translations['antibody.pdp.commerceCard.promotion.viewpromo']}}
{{$productOrderCtrl.translations['antibody.pdp.commerceCard.promotion.promocode']}}: {{promo.promoCode}} {{promo.promoTitle}} {{promo.promoDescription}}. {{$productOrderCtrl.translations['antibody.pdp.commerceCard.promotion.learnmore']}}
产品信息
20767-1-AP
种属反应
宿主/亚型
分类
类型
抗原
偶联物
形式
浓度
规格
纯化类型
保存液
内含物
保存条件
运输条件
产品详细信息
Immunogen sequence: TPLWRLSYE EQLKVKFAAQ KKILQRLESY IQMLNGVSVT TAVPKSERLS CLLHPIIPSP VINGYRNKST FSVNRGPDGN PKTVGFYLGT WRDGNVVCVQ SNHLKNIPEK HSQVAQYYEV FLRQSPLEPC LVFHEGGYWR ELTVRTNSQG HTMAIITFHP (89-247 aa encoded by BC007526)
靶标信息
Probable S-adenosyl-L-methionine-dependent methyltransferase that catalyzes the formation of 5-methyl-uridine at position 54 (m5U54) in all tRNA. May also have a role in tRNA stabilization or maturation.
仅用于科研。不用于诊断过程。未经明确授权不得转售。
篇参考文献 (0)
生物信息学
蛋白别名: rRNA (uracil-5-)-methyltransferase TRMT2B; TRM2 homolog; TRM2 homolog B; TRM2 tRNA methyltransferase 2 homolog B; tRNA (uracil(54)-C(5))-methyltransferase homolog; tRNA (uracil-5-)-methyltransferase homolog; tRNA (uracil-5-)-methyltransferase homolog B; tRNA methyltransferase 2 homolog B; unnamed protein product
基因别名: CXorf34; dJ341D10.3; TRMT2B
UniProt ID: (Human) Q96GJ1
Entrez Gene ID: (Human) 79979